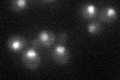
YIL143C
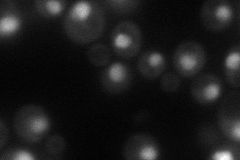
YIL143C
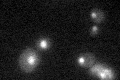
YIL143C

View description
Component of the holoenzyme form of RNA polymerase transcription factor TFIIH, has DNA-dependent ATPase/helicase activity and is required, with Rad3p, for unwinding promoter DNA; involved in DNA repair; homolog of human ERCC3
Localization:
Intensity:
Fold change:
Significance:
-
C’ GFP library in SD
nucleus34.49 -
N' NOP1pr-GFP in SD
nucleus55.7205 -
N' TEF2pr-mCherry in SD

nucleus17.0413 -
N' NATIVEpr-GFP in SD

nucleus28.9894 -
N' TEF2pr-VC and Cyto-VN in SD

nucleus27.213 -
C’ GFP library in SD+DTT

nucleus36.871.06No -
C’ GFP library in SD+H2O2

nucleus37.551.08No -
C’ GFP library in Starvation Media
nucleus28.330.82No -
C’ GFP library on the background of Pup2-DaMP

nucleus, cytosol -
C’ GFP library on the background of CCT mutant

nucleus50.8431.47385Yes
